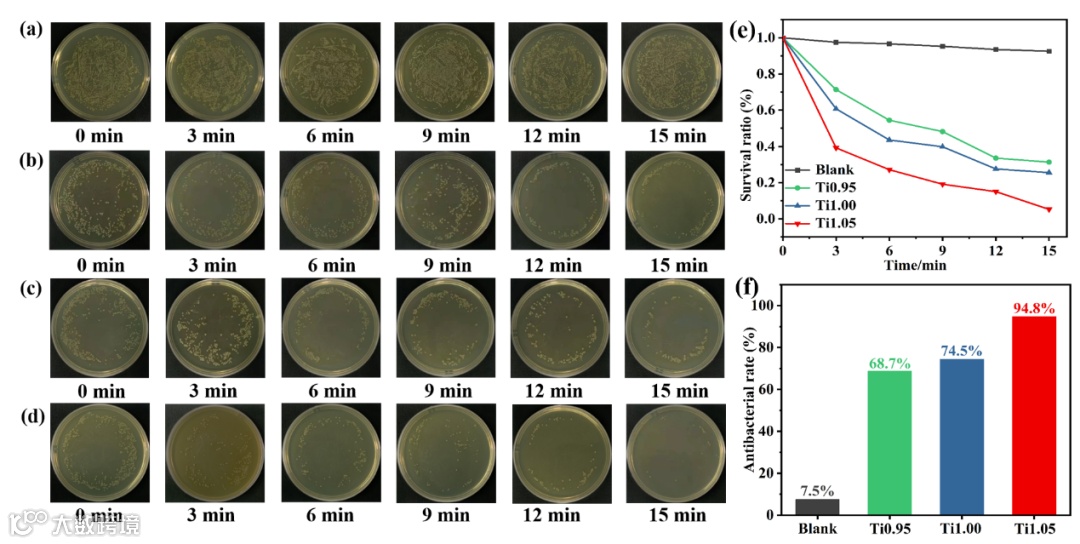

通讯单位:陕西科技大学材料科学与工程学院、广西大学物理科学与工程技术学院
论文DOI:10.1021/acsami.2c12026

全文速览
本论文以铋层状铁电化合物Bi3TiNbO9为研究对象,提出一种简洁有效的自掺杂策略,通过控制类钙钛矿层中B位原子Ti和Nb的原子比,实现对Bi3TiNbO9纳米片{001}和{110}晶面暴露比的调控。当Ti/Nb原子比增加时(Ti1.05),纳米片暴露更多的{110}晶面。结合理论计算和光沉积实验,证实{001}和{110}晶面间形成了晶面异质结,光生电子聚集在{110},而光生空穴聚集在{001},促进了光生电荷的空间分离性,Ti1.05样品具有最佳的晶面暴露比和晶面异质结效果。此外,由于Ti4+不等价取代Nb5+诱导产生氧空位,同时电滞回线证实在Ti1.05样品中铁电性能得以提高,以上这些因素协同提升光生电荷的分离和转移,从而改善了光催化降解有机物污染物和抗菌性能。


背景介绍
构建晶面异质结被证明是促进半导体光催化剂中载流子分离,抑制电子空穴复合的有效方法,已被成功应用在改善半导体光催化和光电催化性能等领域。然而与已报道的半导体光催化剂的众多体系相比,晶面异质结的应用体系还很有限。这可能与晶面生长机理的不明晰以及有限的晶面控制方法有关。传统的晶面调控方法主要包括调控液相反应介质的pH、添加表面活性剂、掺杂异质原子等。因此,开发调控晶面暴露比的新策略,拓展晶面异质结的应用体系,并在微观尺度揭示晶面异质结对载流子动力学的影响机理是有必要并且十分重要的。
近年来铋层状结构铁电体因其自发极化内建电场和典型的层状结构而受到光催化领域研究者的关注。Bi3TiNbO9作为其中的一员,被报道应用在光分解水、光还原二氧化碳等领域。同时有报道指出可以通过改变合成温度来调控Bi3TiNbO9的晶面暴露比,但缺乏晶面工程对载流子动力学更深入的机理研究和探讨。对于Bi3TiNbO9的掺杂改性,之前的研究主要集中在异质原子掺杂调控其能带结构或实现缺陷工程,例如Fe、Ni等。考虑到在Bi3TiNbO9的类钙钛矿层中Ti和Nb等比例占据B位,因此能否通过自掺杂的方式,即通过调控二者的原子比改变特定晶面的自由能,实现对晶面暴露的控制,构建并优化晶面异质结,是一个有趣的值得研究的问题。

本文亮点
1. 基于自掺杂策略,通过改变Ti/Nb原子比实现对Bi3TixNb2-xO9(x=0.95, 1.00, 1.05)纳米片{001}和{110}晶面暴露比的调控
2. 结合DFT理论计算和光沉积实验证实了{001}和{110}晶面异质结的形成
3. Ti1.05样品具有最佳的光降解和抗菌性能,这得益于其良好的光生电荷分离和迁移等动力学特性,而这一特性归因于最佳的晶面暴露比和异质结效果,以及Ti取代Nb诱导产生的氧空位和增强的铁电性能

图文解析

图1 (a) Ti0.95, Ti1.00和 Ti1.05的XRD图谱;(b) (115) 衍射峰的放大图;(c) 样品的晶胞参数;(d) (004)和(220)衍射峰的相对强度;(e) 样品{001}与{110} 晶面的强度比。随着Ti/Nb原子比的增加,即Ti取代部分Nb,(115) 衍射峰向高角度偏移,(004)衍射峰相对强度逐渐下降,而(220)衍射峰相对强度增强,意味着{001}/{110}晶面暴露比逐渐下降。

图2 (a) Ti1.05纳米片的透射电镜图;(b)对应的高分辨透射图及晶格条纹;(c)选区电子衍射;(d) 纳米片晶体的晶面示意图。纳米片的上下表面对应{001}晶面,侧面对应{110}晶面。

图3 样品的SEM/EDS图。根据SEM图片统计计算样品的{001}和{110}晶面的暴露比,发现{110}晶面的暴露比从Ti0.95的14.6%增加到Ti1.05的17.9%,与XRD结果一致。同时EDS成分分析显示样品中Ti/Nb原子比从Ti0.95到Ti1.05递增。

图4 样品的XPS以及EPR图谱。根据XPS的峰强度,Ti和Nb的原子比从Ti0.95到Ti1.05逐渐升高,与SEM/EDS的结果保持一致;此外,EPR证实不等价替换诱导产生氧空位。

图5 光催化降解有机污染物罗丹明B(a)、盐酸四环素(b)和环丙沙星(c)的降解曲线。Ti1.05展示了优于其他两个样品的光催化性能和良好的循环稳定性 。
图6 三个样品在光照条件下对大肠杆菌的抗菌效果,(a)-(d)分别对应空白实验、Ti0.95、Ti1.00和Ti1.05。Ti1.05展示了最佳的抗菌效果。

图7 样品的荧光光谱图、时间分辨荧光光谱、I-V曲线、光电流、EIS以及表面光电压。综合以上的表征结果,证实Ti1.05的光生电荷分离和传输效率最高。

图8 光沉积 (a)Ag, (b)MnOx的 SEM图片以及光沉积Ag的TEM图片(c),证实Ag倾向于沉积在纳米片的侧面,MnOx沉积在上下表面。(d) 光降解NBT实验,(e-f) 光照下三个样品的•O2-的产量以及EPR信号对比;(g) 光沉积MnOx的含量对比。证实Ti1.05在同样的条件下能够产生更多的电子和空穴。

图9 DFT计算(110)面在Ti取代Nb前后的最佳构型及表面能,(a)掺杂前,(b)掺杂后; 两个晶面的功函数(c) (001)和 (d) (110);(e) (001) 和(110)的DOS 图;(f) {001}和{110}晶面异质结示意图。结合理论计算和光沉积实验结果,Ti取代Nb更有利于{110}晶面暴露,这与XRD结果保持一致,同时(110)晶面的功函数相对更大,更利于聚集电子,两个晶面的DOS图也证实二者能够形成异质结,促进光生电子转移到{110},光生空穴聚集到{001}。

图10 样品降解RhB(a-c)和CIP(d-f)的捕获实验结果,(g)提出的机理示意图。捕获实验证实空穴和•O2-在降解有机物中起主导作用。在晶面异质结、氧空位和铁电极化场的作用下,Ti1.05的光生电荷被有效空间分离,获得了优异的光催化降解和抗菌性能。

总结与展望
本研究通过控制Ti/Nb原子比获得了自掺杂Bi3TixNb2-xO9纳米片。结合XRD和SEM表征证实Ti/Nb原子比的改变能够有效调控{001}和{110}晶面暴露比,提高Ti原子含量,纳米片暴露更多的{110}晶面。结合光沉积实验和DFT理论计算,{001}和{110}晶面构成晶面异质结,光生电荷能够有效空间分离。当x=1.05时,样品展示了最佳的光降解和抗菌性能。基于荧光光谱、光电化学、表面光电压和EPR等表征结果,Ti1.05具有最高的载流子分离效率和输运特性,这归因于其具有最佳的晶面暴露比和晶面异质结效果。同时Ti1.05中自掺杂产生的氧空位和增强的铁电性能也进一步优化了光生电荷的传输特性。这一工作提供了一种简便高效的自掺杂策略同时实现对晶面异质结、缺陷和铁电性能的调控,有望加深对铋层状铁电光催化剂晶面工程的认知。

作者介绍
崔永飞,陕西科技大学副教授,硕士研究生导师。博士毕业于英国伦敦玛丽女王大学。主要从事新型铁电、压电及光(电)催化材料的设计、开发及在能源和环境中的应用。近年来在Chemistry of Materials、ACS Applied Materials & Interfaces、Applied Materials Today、Langmuir等国外知名学术期刊发表学术论文30余篇。
陶小马,广西大学教授,博士研究生导师。博士毕业于中南大学,法国蒙彼利埃二大博士后,西班牙马德里先进材料研究所访问科学家。主要从事密度泛函理论计算工作和新型合金性能与设计工作。在Physical Review B、Nano Energy、ACS Applied Materials & Interfaces、Intermetallics、Journal of Physical Chemistry A 等国内外知名学术期刊发表学术论文140余篇,H因子21。
本文仅供科研分享,不做盈利使用,如有侵权,请联系后台小编删除
欢迎关注我们,订阅更多最新消息
“邃瞳科学云”推出专业的自然科学直播服务啦!不仅直播团队专业,直播画面出色,而且传播渠道多,宣传效果佳。
“邃瞳科学云"平台正在收集、整理各类学术会议信息,欢迎学会、期刊、会议组织方择优在邃瞳平台上进行线上直播,希望藉此帮助广大科研人员跨越时空的限制,实现自由、畅通地交流互动。欢迎老师同学们提供会议信息(会有礼品赠送),学会、期刊、会议组织方商谈合作,均请联系翟女士:18612651915(微信同)。
投稿、荐稿、爆料:Editor@scisight.cn